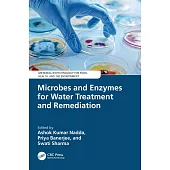
Microbes and Enzymes for Water Treatment and Remediation

Water Sustainability and Hydrological Extremes: Quantity, Quality, and Security presents a study for the mitigation of h......more

The universal goal at utilities is to have every employee, every day, return home to his or her family uninjured. We bel......more

Fundamentals of Evapotranspiration aims to determine simple methods to evaluate evapotranspiration and to examine the ev......more

An excellent guide for anyone with a water system or water system problem, Water Quality and Systems provides an A-Z ref......more

Phycoremediation of Wastewater: Practical Applications for Sustainability focuses on the latest developments in water re......more

Well activation is one of the most important aspects in the oil and gas industries and nitrogen gas is predominately use......more

This report explains why women in Asia and the Pacific are more likely to suffer water insecurity, shows how it impacts ......more

Volume 3 provides an overview of good practice solutions, considerations, and lessons learned for building back better i......more

Florida’s Water poses fundamental questions about water sustainability in the United States’ fourth largest state. Flori......more

As a water-scarce state with deep cultural attachments to private property rights, Texas has taken a unique evolutionary......more

A practical guide to determining catchment yield and the amount of water required in a dam. Also advises on working with......more

Drought is one of the likely consequences of climate change in many regions of the world. Together with an increased dem......more

Minnesota has a unique role in U.S. water policy. Hydrologically, it is a state with more than 12,000 lakes, an inland s......more

This book explores the interconnections of internal phosphorus loading, cyanobacteria, and climate change and their role......more

This book ’Extremophiles: Wastewater and Algal Biorefinery’ explores the potential of extremophiles/extremotolerant orga......more

Focussing on microbial community structure in the field of wastewater treatment, it highlights structure analyses in rel......more

This volume highlights advanced algal based technologies for wastewater treatment alongwith the opportunities that the e......more

This holistic book covers the richest area in North East India in terms of both explored and foreseen reserves of fossil......more

This book shows, through real and current examples from the field of environmental and wetland science, that personal an......more

This text presents recent research and advances in various solid-liquid separation technologies and their applications t......more

Nanoscience-technology is playing vital role in multidisciplinary research due to its unique characteristics at nanoscal......more

This book explores recent developments in the use of advanced nanomaterials (ANMs) for water treatment and remediation. ......more

The book offers a comprehensive review of the latest advances in nanomaterials-based technologies for the treatment of e......more

Advanced Materials for Wastewater Treatment and Desalination: Fundamentals to Applications offers a comprehensive overvi......more

This book highlights the innovations and techniques to identify and treat the emerging pollutants in waste and polluted ......more

This book combines state-of-the-art numerical and experimental techniques applied to water to understand its puzzling pr......more

This book discusses advanced materials and technologies used in wastewater treatment. It includes the treatment of waste......more

Environmental Impacts of Hydraulic Fracturing is a balanced and comprehensive guide to all aspects of hydraulic fracturi......more

The book provides up-to-date insights into the potential of microbial and enzyme-based processes for wastewater treatmen......more

This book is intended to help water and wastewater utility managers and operators navigate the complex world of cybersec......more

Rainwater Harvesting for the 21st Century serves as a rigorous yet practical guide for a broad audience interested in th......more

The aim of the book is to make the water sector professionals working on the legal and regulatory aspects of water-relat......more

The Science of Water Reuse explains how technology can sufficiently purify reclaimed water to potable water quality- eve......more

Nestled amidst rolling hills, Shillong, the Himalayan capital city of Meghalaya in India’s northeast, faces a growing ch......more

Qanats are ubiquitous, yet unseen, and a clever way to create streams where none exist in nature. For 3,000 years, they ......more

Water Matters: Achieving the Sustainable Development Goals presents a compilation of water scenarios and their relations......more

Water Resources Monitoring, Management, and Sustainability: Application of Geostatistics and Geospatial Modeling, Volume......more

Emergency Management Threats and Hazards: Water is a resource guidebook, which bridges the work of the emergency managem......more

This book is a unique text that explores recent research on the management of groundwater sustainable use in the North C......more

This technical report assesses the string of events that triggered Nepal’s Melamchi River floods in 2021 and highlights ......more

In the Asia and Pacific region, accessing clean water and sanitation is a constant challenge for residents of informal s......more

Water Footprints and Sustainable Development serves as the sole comprehensive volume of the role of waste management for......more

Climate change not only involves rising temperatures but it can also alter the hydro-meteorological parameters of a regi......more

Climate change not only involves rising temperatures but it can also alter the hydro-meteorological parameters of a regi......more

Climate change not only involves rising temperatures but it can also alter the hydro-meteorological parameters of a regi......more

Based on the author’s more than 40 years of experience working on environmental projects, Remediation Manual for Contami......more

Adsorption is one of the method that is in use for remediation of contaminated water. The experimental factors affecting......more

This book provides hydrologists the information needed for the characterization of contaminated subsurface hydrologic si......more

Here is a comprehensive volume on this important topic. It broadly covers the sources, availability, demand, and supply ......more

Urban and Industrial Water Conservation Methods provides comprehensive and practical information regarding water use for......more

Fundamentals of Public Utilities Management provides practical information for constructing a roadmap for successful com......more

Water and wastewater infrastructure are a somewhat invisible, yet critical, part of modern life. Incredibly, many buried......more

Land use and water resources are two major environmental issues which necessitate conservation, management, and maintena......more

It is common practice to evaluate wastewater to understand drug consumption, from antibiotics to illegal narcotics, and ......more

This book serves as a technical yet practical risk management manual for professionals working with water and wastewater......more

This book presents three distinct pillars for analysis, design, and planning: urban water cycle and variability as the s......more

Floods are difficult to prevent but can be managed in order to reduce their environmental, social, cultural, and economi......more

Real risk management is predicated on the eventuality of human erraticism and therefore necessitates the design of resil......more

Floods are difficult to prevent but can be managed in order to reduce their environmental, social, cultural, and economi......more

Floods are difficult to prevent but can be managed in order to reduce their environmental, social, cultural, and economi......more

This book provides comprehensive analysis of a number of groundwater issues, ranging from flow to pollution problems. Se......more

Details research on sustainable water treatment and ecosystem protection strategies. Reviews new advances in pollution c......more

The reclamation of wastewater (and other essential materials) is among the major research areas for understanding the ef......more

This book discusses the sources, mechanism, impact and abatement of pollution in waterbodies and lays a base foundation ......more

Anammox Process: Technological Advancement and Application in Industrial Wastewater Treatment Plant systematically summa......more

In arid and semi-arid regions, where water demand exceeds water availability, water security is becoming a significant c......more

Vortex Chronicles: An Anthology on Tropical Storm Dynamics and Impacts offers an extensive collection of scientific jour......more

Tides of Change: Navigating Flood Risks and Climate Impacts provides a comprehensive examination of the multifaceted ris......more

Vortex Chronicles: An Anthology on Tropical Storm Dynamics and Impacts offers an extensive collection of scientific jour......more

Voices from the Depths: Global Insights on Water Contamination is a seminal compilation of scholarly articles addressing......more

Voices from the Depths: Global Insights on Water Contamination is a seminal compilation of scholarly articles addressing......more

Tides of Change: Navigating Flood Risks and Climate Impacts provides a comprehensive examination of the multifaceted ris......more

Standards for Operation of Nutrient Removal Facilities, WEF 37-24, covers the fundamental biological and chemical proces......more

As automation continues to be a growing component of the water industry, new technologies and applications are constantl......more

Introduce the young explorer in your life to the thrill of outdoor adventure with "Wilderness Survival for Kids"! This g......more

The Privatization of Water: Commodifying a Basic Right provides a comprehensive analysis of the global water crisis, exp......more

This book explores how the landscapes in indigenous territories are rapidly changing due to increased global industrial ......more

This new edition of The Drinking Water Handbook is thoroughly revised and updated and includes a comprehensive discussio......more

Immunocompromised persons are more vulnerable than the general population to contaminants in drinking water and include ......more

The book contains a lot of basic knowledge in the field of hydrology and contains valuable research in the area of water......more

Development in Waste Water Treatment Research and Processes: Role of Environmental Microbiology in Industrial Wastewater......more

Membrane bioreactors have reached a level of maturity where the technology is regularly implemented for the treatment of......more

Water Security: Big Data-Driven Risk Identification, Assessment and Control of Emerging Contaminants contains the latest......more

Microbial systems have a strong potential to develop green and sustainable technologies, including sources of renewable ......more

Explores the growing water supply crisis through an ethnographic study of a rural minority community in China threatened......more

The fourth edition incorporates findings and data from the 2020 WRF project 4689 study; the 2016 "Residential End Uses o......more

From 1907 to 1967, a network of reservoirs and aqueducts was built across more than one million acres in upstate New Yor......more

Fully revised and updated, this authoritative volume offers the most comprehensive information available on maintenance,......more

The Dynamics of Water Innovation is an invaluable resource for individuals and organizations driving the adoption of new......more

This book works to build trust, consensus, and capacity to enhance understanding through a water conflict management fra......more

The 2nd edition of Fundamentals of Wastewater Treatment and Design introduces readers to the fundamental concepts of was......more

This is a comprehensive resource that integrates the application of innovative remote sensing techniques and geospatial ......more

Embrace the Rain: Unveil Nature’s Lifesaving Secrets & Master the Art of Water Survival Two manuscripts in one book: Har......more

Environmental Approach to Remediate Refractory Pollutants from Industrial Wastewater Treatment Plants discusses the emer......more

This book presents a comprehensive view of the different theories of risk management in water, drawing on recent studies......more

���� Welcome to "Solar Energy: Sun Power Unleashed" ���� Unlock the power of the sun with our comprehensive book bundle!......more

���� Welcome to the Renewable Energy 101 Book Bundle! ���� Are you ready to unlock the power of renewable energy and sha......more

Water resource management consists of planning, developing, distributing and managing the available water resources. Wit......more

Transform Your Property into a Self-Sustaining Oasis! Ever gazed at the sky during a downpour and dreamed of turning tho......more
The tireless resistance of local communities fighting for ownership of America’s third largest water system. Toxic Water......more